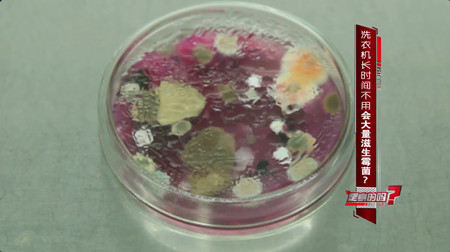
洗衣机长期不洗霉菌,洗衣机放在潮湿的环境有霉菌

网传,洗衣机用一段时间里面就特别脏,会滋生细菌。这是真的吗?

洗衣机放置一段时间再使用真的容易滋生细菌吗?央视“是真的吗”栏目记者前往具有检测资质的第三方机构北京北京科卓检测技术有限公司,对一周未使用、两周未使用、两个月未使用的洗衣机进行入户采样。


北京科卓检测技术有限公司工程师朱暹明说,霉菌属于真菌的一种,生长在阴暗、潮湿、温暖的地方,洗衣机符合霉菌生长的环境,本次检测的是洗衣机内是否有霉菌。

首先,工作人员对三个洗衣机的内桶壁进行采样。随后放水,模拟洗衣服的过程,并对洗衣水进行采样。 随后对六个样品进行检测。洗衣机的桶壁上会检出霉菌吗?

朱暹明说,桶壁上均未发现霉菌。一周、两周、两个月未使用的洗衣机里都没有生长霉菌。这是不是意味着这三个洗衣机都很干净呢?
朱暹明说,桶壁比较干燥,不利于霉菌的生长,可能没有检测出来。但是不能代表洗衣机的沟壑或下水管路中没有霉菌。
由于洗衣机的构造比较复杂,机箱内有很多我们直接看不见的地方也可能滋生污垢,在洗衣服的时候,这些污垢会不会进入到洗衣服的水里呢?
从洗衣水的检测结果来看,一周未使用的洗衣机里面每毫升有5个菌落,两周未用的洗衣机里面每毫升有6个菌落,两个月未使用的洗衣机里面菌落数多不可计。这些霉菌会对人体造成什么样的影响呢?
第二炮兵总医院皮肤科主任医师杨维玲说,霉菌会引发一些皮肤疾病,如果把内衣*裤内**都放在洗衣机里面洗,可能也会传染上霉菌性疾病。像霉菌性阴道炎、*头龟**炎、皮肤过敏性疾病,比如慢性*麻疹荨**等。

杨维玲还说,霉菌对孩子的影响远高于成人。霉菌感染一般跟免疫功能有关,免疫功能强的人可能受感染机会小。孩子的免疫功能相对较弱,所以受感染的几率比较大。
记者找来了专业的清洗工程师拆洗洗衣机。
家电管家清洗工程师管恩才说,洗衣机最脏的地方是内桶跟外桶中间的夹层,平时用肉眼是看不到的,洗衣机的下水回路也是容易滋藏污垢的地方。

除了专业清洗之外,在日常使用中有没有方法可以保持洗衣机的清洁呢?

管恩才说,洗衣机日常保养的方法有以下几点: 一、每次洗完衣服之后大概30分钟以后再把上盖关上,避免里面滋生细菌;二、每周把里面的过滤网跟过滤盒拿出来清洗一下;三、定期用84消毒液在洗衣机里清洗过滤,也可以起到消毒杀菌的作用。(实习生崔智临)
